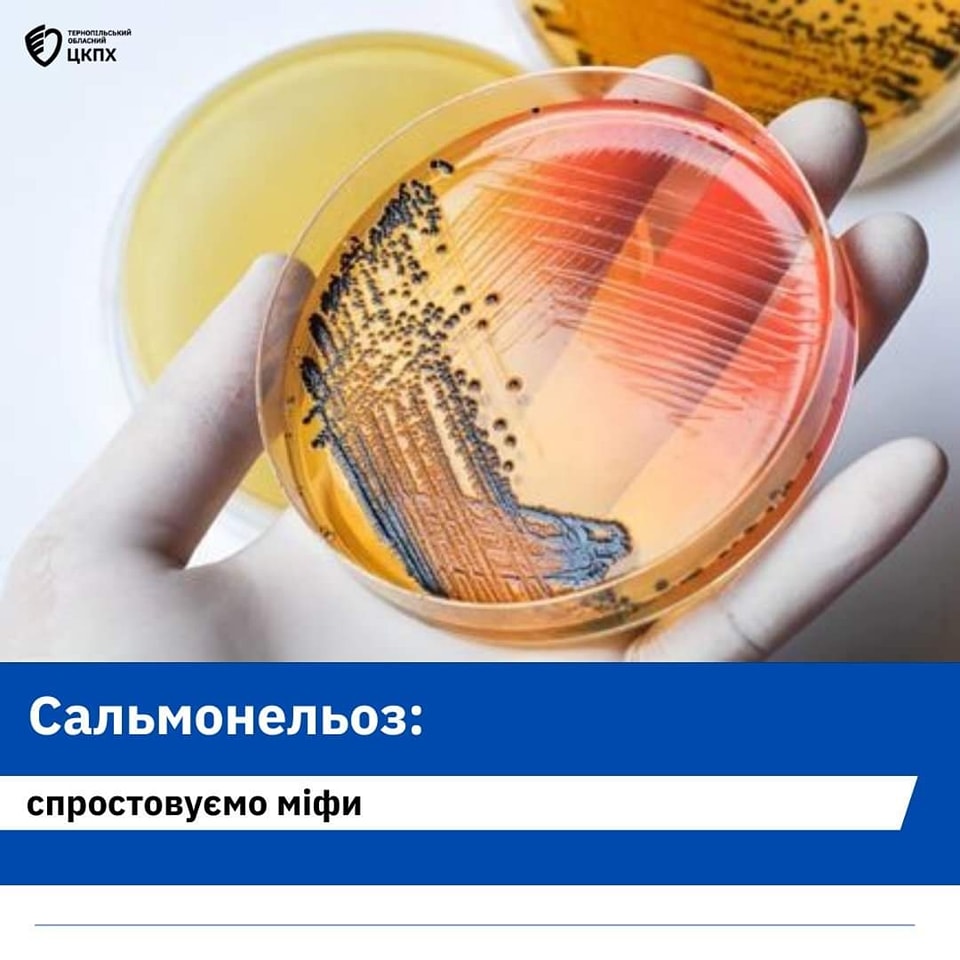

Сальмонельоз: спростовуємо міфи
24 червня 2024Що нам відомо про сальмонельоз?
Здебільшого те, що це небезпечне інфекційне захворювання, яким можна заразитися, вживаючи в їжу сирі яйця, а також погано проварену або просмажену курятину. А ось перепелині яйця, як вважають деякі люди, можна їсти сирими, тому що сальмонели в них не живуть.
✖︎ Міф перший. Джерелом інфекції є яйця
✔︎ Джерелом інфекції є кури. У свіжих яйцях сальмонели немає. Однак, частинки посліду курки, що містять бактерії, можуть потрапити на шкаралупу. Через деякий час (від 4 годин до 5 діб) бактерії проникають через шкаралупу всередину яйця і інфікують його. Тому, перед використанням яйця потрібно ретельно вимити водою з милом.
✖︎ Міф другий. Джерелом інфекції є тільки домашня птиця
✔︎ Це омана. Крім курей, сальмонельоз переносять велика рогата худоба, вівці, кози і навіть свині. Також резервуаром інфекції є гризуни, дикі птахи (горобці, голуби, чайки, снігурі), устриці, молюски, гусениці, таргани, мухи, бджоли, жаби, черепахи, риби, змії.
✖︎ Міф третій. У морозилці сальмонела гине
✔︎ Бактерії сальмонели дуже витривалі. У воді вони можуть виживати 5-6 місяців, у м’ясі і ковбасі – 3-4 місяці, у морозилці можуть зберігатися близько півроку, а у заморожених тушках птахів – навіть понад рік (дуже низькі температури, навпаки, консервують сальмонели, залишаючи їх життєздатними).
✖︎ Міф четвертий. Смажені яйця можна їсти без побоювання заразитися
✔︎ Дійсно, у результаті термічної обробки збудник гине. Але яєчню можна сміливо їсти лише в тому разі, якщо підсмажити її з двох боків. А ось оката яєчня залишається такою ж небезпечною, як і свіжі яйця.
✖︎ Міф п’ятий. Перепелині яйця не містять сальмонелу
✔︎ Насправді птахи заражаються внаслідок неякісного годування і неправильного догляду. У більшості випадків головне джерело інфікування – комбікорм, в який входить перероблена тваринна сировина (здебільшого великої та дрібної рогатої худоби, свиней). Тому, якщо такий корм давати перепілкам і якщо вони будуть міститися в пташнику, де порушується мікроклімат (дуже спекотно), то сальмонели можуть з’явитися і в перепелиних яйцях.
✖︎ Міф шостий. Ніж, після того як ним різали сире м’ясо, достатньо помити холодною водою .
✔︎ Таким чином (через кухонний інвентар) заразитися сальмонельозом дуже легко. Адже в сирому м’ясі можуть міститися бактерії. Тому, буде недостатнім, якщо ножа і обробну дошку помити холодною водою. Щоб знешкодити збудника, кухонний інвентар необхідно обдати окропом. Але краще для м’яса виділити окремий ніж і окрему кухонну дошку.
✖︎ Міф сьомий. Вилікуватися від сальмонельозу можна самостійно, достатньо прийняти антибіотики
✔︎ Сальмонельоз – важка інфекційна хвороба, яка за неправильного лікування може перейти в хронічну форму. Тому, обов’язково необхідно пройти повний курс стаціонарного лікування. У жодному разі не слід займатися самолікуванням і приймати антибіотики – більшість збудників, які викликають кишкові інфекції, до них стійкі. У результаті неправильного лікування, людина може перетворитися на прихованого носія інфекції і заражати інших. Тому, якщо є ознаки захворювання, обов’язково зверніться до лікаря